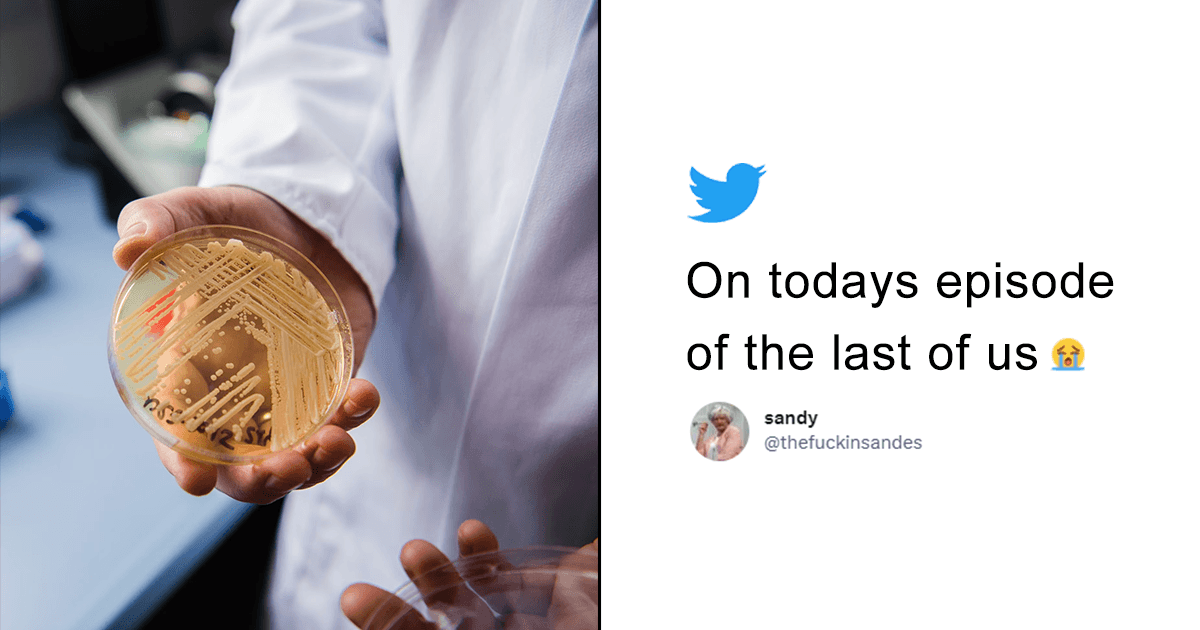
‘The Last Of Us’ Much? A Fungal Infection Is Spreading In USA & The Internet Wants Joel

The Last of Us
Health
‘The Last Of Us’ Much? A Fungal Infection Is Spreading In USA & The Internet Wants Joel
about 3 years ago | 2 min read
Entertainment
12 Moments From ‘The Last of Us’ That Were So High On Emotion That They Made Our Hearts Ache
over 3 years ago | 6 min read
Entertainment
8 Reasons Why ‘The Last Of Us’ Is The Best Show On TV Right Now
over 3 years ago | 4 min read